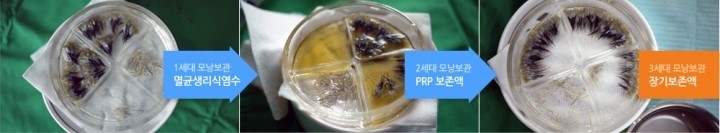

선천적으로 조직의 특성상 모낭 조직이 미끄러운 경우가 있습니다.
세척해도 쉽게 사라지지 않는 점액성 오일막이 형성되어 이식 시간이 길어지고 난이도도 높아집니다.
- 모낭을 채취하고 분리하는 과정에서 이미 미끄럽고, 각각의 모낭을 수술도구로 잡기가 어려워 다루는 과정에서 손상이 발생할 가능성이 높아집니다.
- 미끄러운 특성이 여러 번 세척을 하더라도 쉽게 사라지지 않습니다.
- 채취한 모낭을 보관하는 보존액 표면에 기름막이 형성됩니다.
- 절개 방식으로 모발이식 수술을 진행할 경우 절개 부위 봉합 과정에서 실에 혈액이 구슬처럼 동그랗게 맺힙니다.
- 두피에 유분이 많거나 지루성 피부염을 앓고 있다고 해서 모낭이 미끄럽지는 않습니다.
- 이식 수술이 끝난 후에 이식모가 튀어나올 수 있습니다. (popping of the grafts)
미끄러운 모낭을 성공적으로 이식하기 위해 다음과 같은 방법을 사용합니다.
- 이식모가 미끄러져 빠져나올 가능성을 고려하여 슬릿의 크기를 평소보다 작게 만듭니다.
- 미끄러운 성질을 줄일 목적으로 너무 여러 번 세척하지 않습니다. 오히려 손상을 입힐 수 있습니다.
- 일반적으로 수술 시간이 50% 가량 늘어나기 때문에 이식량과 밀도를 무리하게 계획하지 않습니다.
포셉의 형태를 개선하거나, 미끄러움을 줄이는데 도움이 될 모낭 보존액 등을 개발하는 방법 등으로 극복해볼 수 있습니다.
-뉴헤어 대머리블로그-
'모발이식' 카테고리의 다른 글
| 처음 모발이식을 하는 의사들이 주의해야 할 사항들 (0) | 2019.06.11 |
|---|---|
| 슬릿 모발이식 때 모낭을 삽입하는 방법들 (0) | 2019.06.11 |
| 모발이식 후 부기 예방법 (0) | 2019.06.07 |
| 모발이식 때 다른 부분에 비해 정수리 부분이 체감 효과가 떨어져 보이는 이유 (0) | 2019.06.07 |
| 비절개 모발이식 시 수술 결과를 좋게 하기 위한 요소들 (0) | 2019.06.05 |